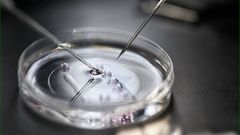

Mulago Specialised Women and Neonatal Hospital is celebrating a new milestone in its medical journey with the delivery of its first successful In Vitro Fertilisation (IVF) baby.
The hospital’s IVF programme, which had made considerable strides in recent months, has now culminated in the birth of a healthy baby girl weighing 3.4 kg.
The announcement was shared by the Ministry of Health through its spokesperson, Emmanuel Ainebyoona.
What is IVF?
&format=jpeg)
IVF process
The IVF process is a form of assisted reproductive technology (ART) where an egg is fertilised outside the body, typically in a laboratory.
An egg is retrieved from a woman's ovaries and fertilised with sperm in a test tube, and the resulting embryo is then transferred into the woman's womb for development.
The introduction of IVF services at Mulago has been a long-awaited development, providing a much-needed avenue for couples struggling with infertility.
Progress and Challenges in IVF Services
Earlier in January 2025, Dr. Evelyn Nabunya, the Executive Director of Mulago Specialised Women and Neonatal Hospital, announced the commencement of IVF services at the facility, with 11 stimulations completed and two successful pregnancies.
&format=jpeg)
Mulago Specialised Women and Neonatal Hospital
While the hospital celebrated these early successes, challenges in funding for medical supplies and reagents were noted, with an urgent need for UGX 1.2 billion to sustain the IVF programme and other essential services.
“To perform a single IVF cycle for one client, we require UGX1.5 million. We urgently need an additional UGX1.2 billion to sustain,” she said.
Despite these financial hurdles, Mulago's fertility programme has made remarkable progress, offering hope to many families in need of advanced reproductive assistance.
With two pregnancies already confirmed and more couples seeking IVF treatments, the hospital's achievement is a promising step towards better healthcare options for those facing infertility.

&format=jpeg)
)
&format=jpeg)
&format=jpeg)
&format=jpeg)